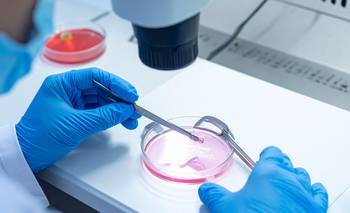

Ingresá con tu usuario/email y contraseña de tu cuenta.
Si aún no te registraste,
REGISTRATE AQUÍ
Temp. Actual
16.2°
S. Térmica
°
Máxima
16°
Mínima
6°
Lluvia
0.0mm.
Viento
3km/h
Un nuevo espacio donde las personas pueden compartir sus pensamientos y perspectivas sobre cualquier tema, desde política y cultura hasta ciencia y tecnología. La plataforma está diseñada para fomentar el diálogo y la discusión constructiva, y para hacerlo, cuenta con una serie de reglas de conducta y moderadores capacitados para garantizar que el intercambio de ideas sea respetuoso y sin violencia.
Las cartas
.
Los hechos ocurridos con los anestesistas en Buenos Aires abre una discusión urgente: el desgaste de los equipos de salud y la falta de dispositivos de cuidado no son problemas individuales, sino fallas del sistema.
.
.
.
Debemos formar ingenieros de campo, capaces de operar y resolver problemas en la realidad física donde la IA todavía no tiene “manos” para actuar.
.
La carne del futuro y el tiempo mal contado.
.
.
.
.
.
.
.
Diagnóstico y cavilaciones de un simple afiliado.
.
.
Resulta esencial que quienes tienen hoy la responsabilidad de gobierno puedan garantizar la transparencia en el uso de todos los recursos económicos.
.
.
.
.
La historia nos pone frente a un espejo incómodo: la desconexión entre adultos y adolescentes en la era digital.
.
.
.
.
.
..
Datos de las 17:30hs.